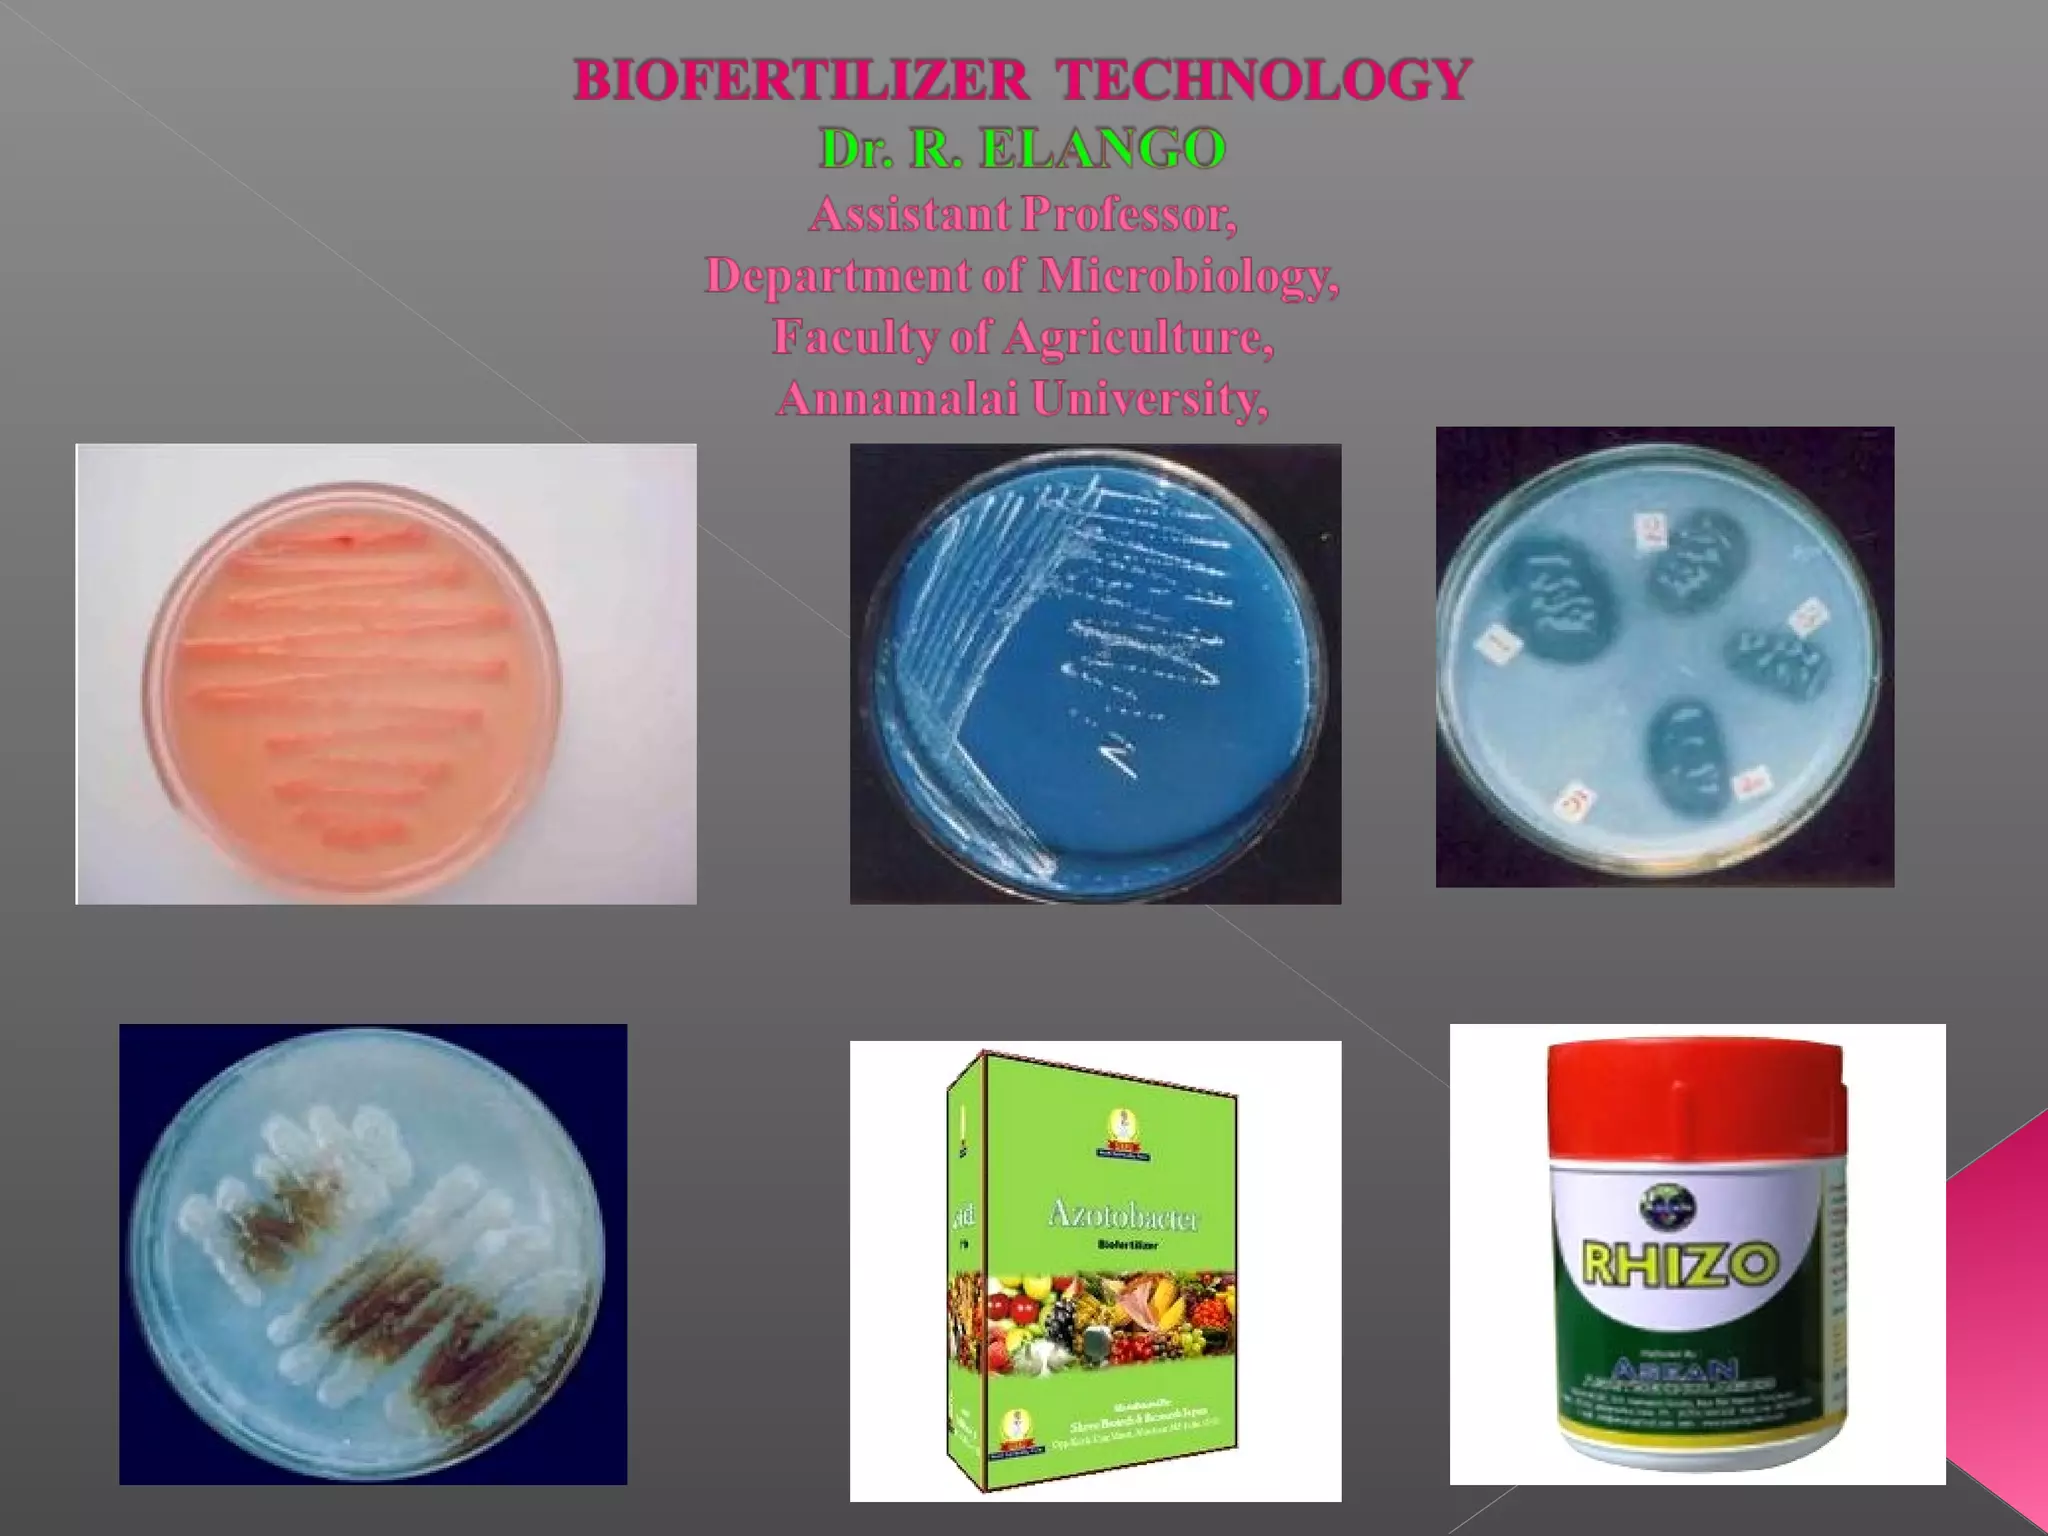

Biofertilizers are microbial preparations that enhance soil fertility by fixing nitrogen, solubilizing phosphorus, and promoting plant growth through their biological activities, serving as a sustainable alternative to chemical fertilizers. They can replace 25-30% of chemical fertilizers and improve soil health while also stimulating plant growth. The production and effectiveness of biofertilizers depend on factors such as microbial strain selection, quality control, and methods of application, with liquid formulations offering advantages over traditional carrier-based systems.